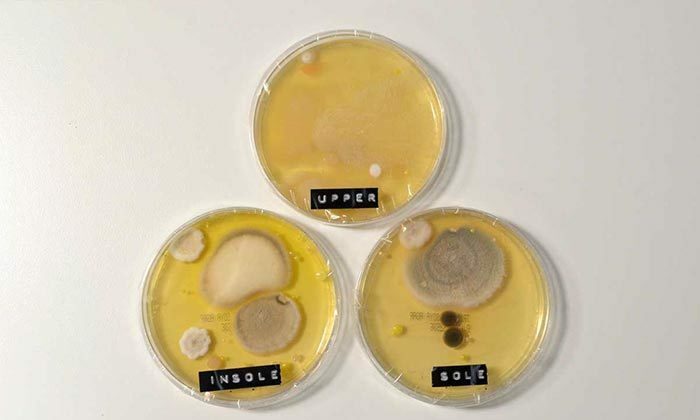

Tiến sĩ Emma Stevenson thuộc Đại học Podiatry ở Anh cho biết, việc mang giày một chân sẽ tạo ra khoảng 500 ml mồ hôi mỗi ngày và sẽ được hấp thụ bởi tất. Nếu bạn không mang vớ, mồ hôi sẽ dính vào giày, gây nhiễm trùng nấm men và mùi khó chịu trên chân. Cô Stevenson nói: “Mang giày không đi tất sẽ làm tăng ma sát giữa bàn chân và giày, gây phồng rộp và hình thành vết chai.” -Công ty giày thể thao châu Âu và nhà khoa học thực thụ. Hiện tại, các thí nghiệm vi khuẩn và khử trùng đã đặt các mẫu dưới kính hiển vi để theo dõi sự phát triển tự do của vi khuẩn mà không cần tất. Do đó, việc tạo ra vi khuẩn và mùi hôi trong mô hình không có vớ nhanh hơn ba lần so với bình thường. Giày không có vớ có thể sống sót 3 lần Ảnh: Highsnobiety
Theo từ điển Sneakers, người chơi trống nói đến đôi giày bạn thường mang bất kể thời tiết. Các nhà khoa học nói rằng những người chơi trống này là môi trường phát triển lý tưởng. Nhiều vi khuẩn có mùi, sau một ngày dài, đặc biệt là không đi tất, giày của bạn sẽ có mùi hơn so với giày thể thao, những đôi giày này cần được làm sạch thường xuyên. Mua và mua giày mới. – “Khi đi tất, mang vớ sẽ làm chậm quá trình bốc mùi. Xin lưu ý rằng bạn thường phải giặt và thay vớ.” Cô Stevenson nói.
Cẩm Anh (theo Highsnobiety)